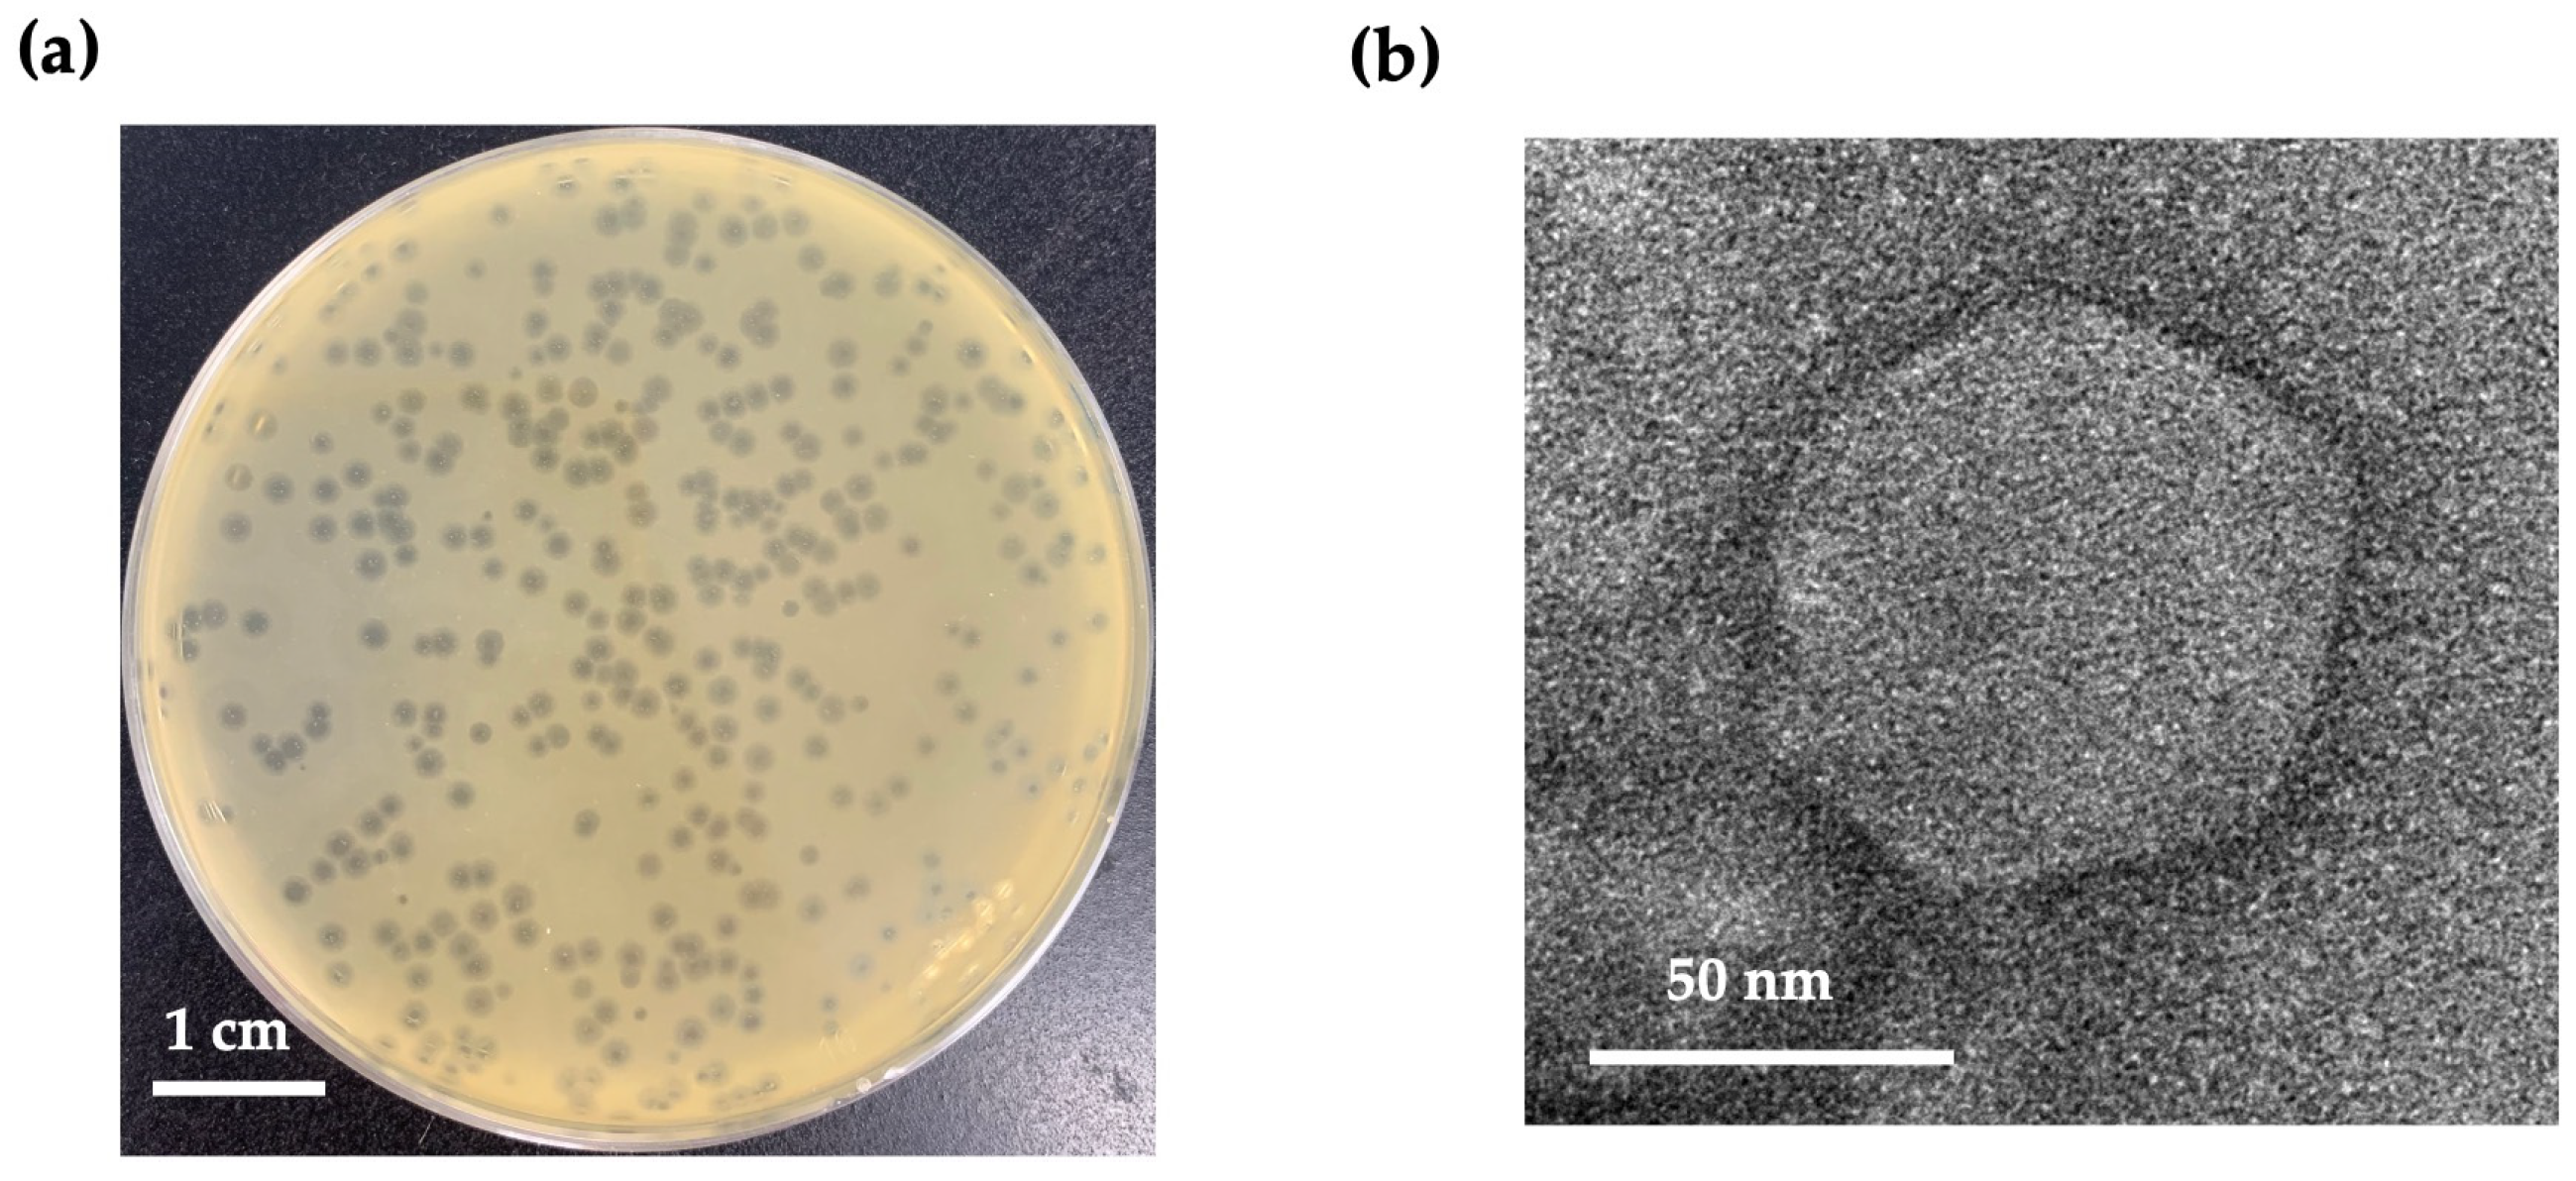
Antibiotics 13 01083 g001

Isolation and Characterization of a Novel Escherichia Bacteriophage with Potential to Control Multidrug-Resistant Avian Pathogenic Escherichia coli and Biofilms
Abstract
1. Introduction
2. Results
2.1. Phage Isolation and Virion Morphology
2.2. Host Range and Efficiency of Plating (EOP) of Phage
2.3. Adsorption of Phage
2.4. One-Step Growth Curve Analysis
2.5. Influence of Phage on Lytic Activity
2.6. Electron Microscopy of APEC Cells Exposed to Phage
2.7. Stability of Phage Under Various Temperatures, pH Values, and Ultraviolet Type C (UVC) Radiation
2.8. Whole-Genome Sequencing and Bioinformatics Analysis
2.9. Evolution of Phage
2.10. The Ability of the Phage to Prevent Biofilm Formation
2.11. The Ability of the Phage to Remove Preformed Biofilms
2.12. SEM Observation of Biofilms
3. Discussion
4. Materials and Methods
4.1. Bacterial Strains and Growth Conditions
4.2. Isolation and Purification of Phage
4.3. Large-Scale Amplification of Phage
4.4. Phage Morphology
4.5. Bacterial Lysis Efficiency
4.6. EOP
4.7. Phage Adsorption Rate Assay
4.8. One-Step Growth Curve
4.9. Inhibition of Planktonic Bacterial Cells by Phage In Vitro
4.10. Visualization of the Phage-Infected Bacterial Cells Under SEM
4.11. Effect of Temperature, pH, and UVC Radiation on Phage Stability
4.12. Whole-Genome Characterization and Analysis
4.13. Prevention of Biofilm Formation by the Phage
4.14. Biofilm Eradication of the Phage
4.15. Observation of Bacterial Biofilm Morphology by SEM
4.16. Accession Numbers of the Genome Data
4.17. Statistical Analyses
5. Conclusions
Supplementary Materials
Author Contributions
Funding
Institutional Review Board Statement
Informed Consent Statement
Data Availability Statement
Conflicts of Interest
References
- Sora, V.M.; Meroni, G.; Martino, P.A.; Soggiu, A.; Bonizzi, L.; Zecconi, A. Extraintestinal Pathogenic Escherichia coli: Virulence Factors and Antibiotic Resistance. Pathogens 2021, 10, 1355. [Google Scholar] [CrossRef] [PubMed]
- Kathayat, D.; Lokesh, D.; Ranjit, S.; Rajashekara, G. Avian Pathogenic Escherichia coli (APEC): An Overview of Virulence and Pathogenesis Factors, Zoonotic Potential, and Control Strategies. Pathogens 2021, 10, 467. [Google Scholar] [CrossRef] [PubMed]
- Joseph, J.; Zhang, L.; Adhikari, P.; Evans, J.D.; Ramachandran, R. Avian Pathogenic Escherichia coli (APEC) in Broiler Breeders: An Overview. Pathogens 2023, 12, 1280. [Google Scholar] [CrossRef]
- Johnson, T.J.; Wannemeuhler, Y.M.; Scaccianoce, J.A.; Johnson, S.J.; Nolan, L.K. Complete DNA sequence, comparative genomics, and prevalence of an IncHI2 plasmid occurring among extraintestinal pathogenic Escherichia coli isolates. Antimicrob. Agents Chemother. 2006, 50, 3929–3933. [Google Scholar] [CrossRef]
- Ewers, C.; Li, G.; Wilking, H.; Kiessling, S.; Alt, K.; Antao, E.M.; Laturnus, C.; Diehl, I.; Glodde, S.; Homeier, T.; et al. Avian pathogenic, uropathogenic, and newborn meningitis-causing Escherichia coli: How closely related are they? Int. J. Med. Microbiol. 2007, 297, 163–176. [Google Scholar] [CrossRef]
- Johnson, T.J.; Wannemuehler, Y.; Doetkott, C.; Johnson, S.J.; Rosenberger, S.C.; Nolan, L.K. Identification of minimal predictors of avian pathogenic Escherichia coli virulence for use as a rapid diagnostic tool. J. Clin. Microbiol. 2008, 46, 3987–3996. [Google Scholar] [CrossRef] [PubMed]
- Hu, J.; Afayibo, D.J.A.; Zhang, B.; Zhu, H.; Yao, L.; Guo, W.; Wang, X.; Wang, Z.; Wang, D.; Peng, H.; et al. Characteristics, pathogenic mechanism, zoonotic potential, drug resistance, and prevention of avian pathogenic Escherichia coli (APEC). Front. Microbiol. 2022, 13, 1049391. [Google Scholar] [CrossRef]
- Cebeci, T. Species prevalence, virulence genes, and antibiotic resistance of enterococci from food-producing animals at a slaughterhouse in Turkey. Sci. Rep. 2024, 14, 13191. [Google Scholar] [CrossRef]
- Manges, A.R.; Johnson, J.R. Food-borne origins of Escherichia coli causing extraintestinal infections. Clin. Infect. Dis. 2012, 55, 712–719. [Google Scholar] [CrossRef]
- Afayibo, D.J.A.; Zhu, H.; Zhang, B.; Yao, L.; Abdelgawad, H.A.; Tian, M.; Qi, J.; Liu, Y.; Wang, S. Isolation, Molecular Characterization, and Antibiotic Resistance of Avian Pathogenic Escherichia coli in Eastern China. Vet. Sci. 2022, 9, 319. [Google Scholar] [CrossRef]
- Bhattarai, R.K.; Basnet, H.B.; Dhakal, I.P.; Devkota, B. Antimicrobial resistance of avian pathogenic Escherichia coli isolated from broiler, layer, and breeder chickens. Vet. World 2024, 17, 480–499. [Google Scholar] [CrossRef] [PubMed]
- Nawaz, S.; Wang, Z.; Zhang, Y.; Jia, Y.; Jiang, W.; Chen, Z.; Yin, H.; Huang, C.; Han, X. Avian pathogenic Escherichia coli (APEC): Current insights and future challenges. Poult. Sci. 2024, 103, 104359. [Google Scholar] [CrossRef]
- Yao, L.; Bao, Y.; Hu, J.; Zhang, B.; Wang, Z.; Wang, X.; Guo, W.; Wang, D.; Qi, J.; Tian, M.; et al. A lytic phage to control multidrug-resistant avian pathogenic Escherichia coli (APEC) infection. Front. Cell Infect. Microbiol. 2023, 13, 1253815. [Google Scholar] [CrossRef]
- Sattar, S.; Bailie, M.; Yaqoob, A.; Khanum, S.; Fatima, K.; Altaf, A.; Ahmed, I.; Shah, S.T.A.; Munawar, J.; Zehra, Q.A.; et al. Characterization of two novel lytic bacteriophages having lysis potential against MDR avian pathogenic Escherichia coli strains of zoonotic potential. Sci. Rep. 2023, 13, 10043. [Google Scholar] [CrossRef]
- Karami, M.; Goudarztalejerdi, A.; Mohammadzadeh, A.; Berizi, E. In vitro evaluation of two novel Escherichia bacteriophages against multiple drug resistant avian pathogenic Escherichia coli. BMC Infect. Dis. 2024, 24, 497. [Google Scholar] [CrossRef]
- Eid, S.; Tolba, H.M.N.; Hamed, R.I.; Al-Atfeehy, N.M. Bacteriophage therapy as an alternative biocontrol against emerging multidrug resistant E. coli in broilers. Saudi J. Biol. Sci. 2022, 29, 3380–3389. [Google Scholar] [CrossRef]
- Nicolas, M.; Trotereau, A.; Culot, A.; Moodley, A.; Atterbury, R.; Wagemans, J.; Lavigne, R.; Velge, P.; Schouler, C. Isolation and Characterization of a Novel Phage Collection Against Avian-Pathogenic Escherichia coli. Microbiol. Spectr. 2023, 11, e0429622. [Google Scholar] [CrossRef]
- Abedon, S.T. Bacteriophage Adsorption: Likelihood of Virion Encounter with Bacteria and Other Factors Affecting Rates. Antibiotics 2023, 12, 723. [Google Scholar] [CrossRef]
- Nicolas, M.; Faurie, A.; Girault, M.; Lavillatte, S.; Menanteau, P.; Chaumeil, T.; Riou, M.; Velge, P.; Schouler, C. In ovo administration of a phage cocktail partially prevents colibacillosis in chicks. Poult. Sci. 2023, 102, 102967. [Google Scholar] [CrossRef] [PubMed]
- Bull, J.J.; Gill, J.J. The habits of highly effective phages: Population dynamics as a framework for identifying therapeutic phages. Front. Microbiol. 2014, 5, 618. [Google Scholar] [CrossRef] [PubMed]
- Liu, C.; Hong, Q.; Chang, R.Y.K.; Kwok, P.C.L.; Chan, H.K. Phage-Antibiotic Therapy as a Promising Strategy to Combat Multidrug-Resistant Infections and to Enhance Antimicrobial Efficiency. Antibiotics 2022, 11, 570. [Google Scholar] [CrossRef]
- Ali, S.; Karaynir, A.; Salih, H.; Oncu, S.; Bozdogan, B. Characterization, genome analysis and antibiofilm efficacy of lytic Proteus phages RP6 and RP7 isolated from university hospital sewage. Virus Res. 2023, 326, 199049. [Google Scholar] [CrossRef]
- Wishart, D.S.; Han, S.; Saha, S.; Oler, E.; Peters, H.; Grant, J.R.; Stothard, P.; Gautam, V. PHASTEST: Faster than PHASTER, better than PHAST. Nucleic Acids Res. 2023, 51, W443–W450. [Google Scholar] [CrossRef]
- Wang, R.H.; Yang, S.; Liu, Z.; Zhang, Y.; Wang, X.; Xu, Z.; Wang, J.; Li, S.C. PhageScope: A well-annotated bacteriophage database with automatic analyses and visualizations. Nucleic Acids Res. 2024, 52, D756–D761. [Google Scholar] [CrossRef] [PubMed]
- Fang, Z.; Feng, T.; Zhou, H.; Chen, M. DeePVP: Identification and classification of phage virion proteins using deep learning. Gigascience 2022, 11, giac076. [Google Scholar] [CrossRef]
- Filik, K.; Szermer-Olearnik, B.; Oleksy, S.; Brykala, J.; Brzozowska, E. Bacteriophage Tail Proteins as a Tool for Bacterial Pathogen Recognition-A Literature Review. Antibiotics 2022, 11, 555. [Google Scholar] [CrossRef]
- Adriaenssens, E.; Brister, J.R. How to Name and Classify Your Phage: An Informal Guide. Viruses 2017, 9, 70. [Google Scholar] [CrossRef]
- Rangel-Pineros, G.; Millard, A.; Michniewski, S.; Scanlan, D.; Siren, K.; Reyes, A.; Petersen, B.; Clokie, M.R.J.; Sicheritz-Ponten, T. From Trees to Clouds: PhageClouds for Fast Comparison of approximately 640,000 Phage Genomic Sequences and Host-Centric Visualization Using Genomic Network Graphs. Phage (New Rochelle) 2021, 2, 194–203. [Google Scholar] [CrossRef]
- Topka-Bielecka, G.; Dydecka, A.; Necel, A.; Bloch, S.; Nejman-Falenczyk, B.; Wegrzyn, G.; Wegrzyn, A. Bacteriophage-Derived Depolymerases against Bacterial Biofilm. Antibiotics 2021, 10, 175. [Google Scholar] [CrossRef] [PubMed]
- Latka, A.; Maciejewska, B.; Majkowska-Skrobek, G.; Briers, Y.; Drulis-Kawa, Z. Bacteriophage-encoded virion-associated enzymes to overcome the carbohydrate barriers during the infection process. Appl. Microbiol. Biotechnol. 2017, 101, 3103–3119. [Google Scholar] [CrossRef] [PubMed]
- Guo, Z.; Huang, J.; Yan, G.; Lei, L.; Wang, S.; Yu, L.; Zhou, L.; Gao, A.; Feng, X.; Han, W.; et al. Identification and Characterization of Dpo42, a Novel Depolymerase Derived from the Escherichia coli Phage vB_EcoM_ECOO78. Front. Microbiol. 2017, 8, 1460. [Google Scholar] [CrossRef]
- Peters, D.L.; Gaudreault, F.; Chen, W. Functional domains of Acinetobacter bacteriophage tail fibers. Front. Microbiol. 2024, 15, 1230997. [Google Scholar] [CrossRef] [PubMed]
- Knecht, L.E.; Veljkovic, M.; Fieseler, L. Diversity and Function of Phage Encoded Depolymerases. Front. Microbiol. 2019, 10, 2949. [Google Scholar] [CrossRef] [PubMed]
- Khan, M.M.; Ali, A.; Kolenda, R.; Olowe, O.A.; Weinreich, J.; Li, G.; Schierack, P. The role of AJB35136 and fdtA genes in biofilm formation by avian pathogenic Escherichia coli. BMC Vet. Res. 2023, 19, 126. [Google Scholar] [CrossRef]
- Young, M.M.; de Oliveira, A.L.; Nolan, L.K.; Barbieri, N.L.; Logue, C.M. Identification of novel genes involved in the biofilm formation process of Avian Pathogenic Escherichia coli (APEC). PLoS ONE 2022, 17, e0279206. [Google Scholar] [CrossRef]
- Ciarolla, A.A.; Lapin, N.; Williams, D.; Chopra, R.; Greenberg, D.E. Physical Approaches to Prevent and Treat Bacterial Biofilm. Antibiotics 2022, 12, 54. [Google Scholar] [CrossRef]
- Korf, I.H.E.; Kittler, S.; Bierbrodt, A.; Mengden, R.; Rohde, C.; Rohde, M.; Kroj, A.; Lehnherr, T.; Fruth, A.; Flieger, A.; et al. In Vitro Evaluation of a Phage Cocktail Controlling Infections with Escherichia coli. Viruses 2020, 12, 1470. [Google Scholar] [CrossRef] [PubMed]
- Thomrongsuwannakij, T.; Narinthorn, R.; Mahawan, T.; Blackall, P.J. Molecular and phenotypic characterization of avian pathogenic Escherichia coli isolated from commercial broilers and native chickens. Poult. Sci. 2022, 101, 101527. [Google Scholar] [CrossRef]
- Wintachai, P.; Naknaen, A.; Thammaphet, J.; Pomwised, R.; Phaonakrop, N.; Roytrakul, S.; Smith, D.R. Characterization of extended-spectrum-beta-lactamase producing Klebsiella pneumoniae phage KP1801 and evaluation of therapeutic efficacy in vitro and in vivo. Sci. Rep. 2020, 10, 11803. [Google Scholar] [CrossRef]
- Wintachai, P.; Phaonakrop, N.; Roytrakul, S.; Naknaen, A.; Pomwised, R.; Voravuthikunchai, S.P.; Surachat, K.; Smith, D.R. Enhanced antibacterial effect of a novel Friunavirus phage vWU2001 in combination with colistin against carbapenem-resistant Acinetobacter baumannii. Sci. Rep. 2022, 12, 2633. [Google Scholar] [CrossRef]
- Myers, J.; Davis Ii, J.; Lollo, M.; Hudec, G.; Hyman, P. More’s the Same—Multiple Hosts Do Not Select for Broader Host Range Phages. Viruses 2023, 15, 518. [Google Scholar] [CrossRef] [PubMed]
- Kutter, E. Phage host range and efficiency of plating. Methods Mol. Biol. 2009, 501, 141–149. [Google Scholar] [CrossRef] [PubMed]
- Kropinski, A.M. Measurement of the rate of attachment of bacteriophage to cells. Methods Mol. Biol. 2009, 501, 151–155. [Google Scholar] [CrossRef] [PubMed]
- Wintachai, P.; Surachat, K.; Singkhamanan, K. Isolation and Characterization of a Novel Autographiviridae Phage and Its Combined Effect with Tigecycline in Controlling Multidrug-Resistant Acinetobacter baumannii-Associated Skin and Soft Tissue Infections. Viruses 2022, 14, 194. [Google Scholar] [CrossRef]
- Montso, P.K.; Mlambo, V.; Ateba, C.N. Characterization of Lytic Bacteriophages Infecting Multidrug-Resistant Shiga Toxigenic Atypical Escherichia coli O177 Strains Isolated From Cattle Feces. Front. Public Health 2019, 7, 355. [Google Scholar] [CrossRef]
- Madeira, F.; Pearce, M.; Tivey, A.R.N.; Basutkar, P.; Lee, J.; Edbali, O.; Madhusoodanan, N.; Kolesnikov, A.; Lopez, R. Search and sequence analysis tools services from EMBL-EBI in 2022. Nucleic Acids Res. 2022, 50, W276–W279. [Google Scholar] [CrossRef]
- Kelley, L.A.; Mezulis, S.; Yates, C.M.; Wass, M.N.; Sternberg, M.J. The Phyre2 web portal for protein modeling, prediction and analysis. Nat. Protoc. 2015, 10, 845–858. [Google Scholar] [CrossRef]
- Ribeiro, J.M.; Pereira, G.N.; Durli Junior, I.; Teixeira, G.M.; Bertozzi, M.M.; Verri, W.A., Jr.; Kobayashi, R.K.T.; Nakazato, G. Comparative analysis of effectiveness for phage cocktail development against multiple Salmonella serovars and its biofilm control activity. Sci. Rep. 2023, 13, 13054. [Google Scholar] [CrossRef]
- Ziuzina, D.; Boehm, D.; Patil, S.; Cullen, P.J.; Bourke, P. Cold Plasma Inactivation of Bacterial Biofilms and Reduction of Quorum Sensing Regulated Virulence Factors. PLoS ONE 2015, 10, e0138209. [Google Scholar] [CrossRef]

| Strain | Phage vECPW8 | |
|---|---|---|
| Lytic Activity | EOP | |
| MDR APEC PW001 | - | - |
| MDR APEC PW002 | + | High (0.8) |
| MDR APEC PW003 | + | High (0.65) |
| MDR APEC PW004 | - | - |
| MDR APEC PW005 * | + | High (Host = 1) |
| MDR APEC PW006 | + | Moderate (0.49) |
| MDR APEC PW007 | - | - |
| MDR APEC PW008 | + | Moderate (0.57) |
| MDR APEC PW009 | - | - |
| MDR APEC PW010 | + | Moderate (0.32) |
| MDR APEC PW011 | - | - |
| MDR APEC PW012 | + | Moderate (0.44) |
| MDR APEC PW013 | + | Low (0.02) |
| MDR APEC PW014 | - | - |
| MDR APEC PW015 | + | Moderate (0.41) |
| MDR APEC PW016 | + | High (0.79) |
| MDR APEC PW017 | - | - |
| MDR APEC PW018 | + | Low (0.03) |
| MDR APEC PW019 | - | - |
| MDR APEC PW020 | - | - |
Disclaimer/Publisher’s Note: The statements, opinions and data contained in all publications are solely those of the individual author(s) and contributor(s) and not of MDPI and/or the editor(s). MDPI and/or the editor(s) disclaim responsibility for any injury to people or property resulting from any ideas, methods, instructions or products referred to in the content. |
© 2024 by the authors. Licensee MDPI, Basel, Switzerland. This article is an open access article distributed under the terms and conditions of the Creative Commons Attribution (CC BY) license (https://creativecommons.org/licenses/by/4.0/).
Share and Cite
Wintachai, P.; Thaion, F.; Clokie, M.R.J.; Thomrongsuwannakij, T. Isolation and Characterization of a Novel Escherichia Bacteriophage with Potential to Control Multidrug-Resistant Avian Pathogenic Escherichia coli and Biofilms. Antibiotics 2024, 13, 1083. https://doi.org/10.3390/antibiotics13111083
Wintachai P, Thaion F, Clokie MRJ, Thomrongsuwannakij T. Isolation and Characterization of a Novel Escherichia Bacteriophage with Potential to Control Multidrug-Resistant Avian Pathogenic Escherichia coli and Biofilms. Antibiotics. 2024; 13(11):1083. https://doi.org/10.3390/antibiotics13111083
Chicago/Turabian StyleWintachai, Phitchayapak, Fahsai Thaion, Martha R. J. Clokie, and Thotsapol Thomrongsuwannakij. 2024. "Isolation and Characterization of a Novel Escherichia Bacteriophage with Potential to Control Multidrug-Resistant Avian Pathogenic Escherichia coli and Biofilms" Antibiotics 13, no. 11: 1083. https://doi.org/10.3390/antibiotics13111083
APA StyleWintachai, P., Thaion, F., Clokie, M. R. J., & Thomrongsuwannakij, T. (2024). Isolation and Characterization of a Novel Escherichia Bacteriophage with Potential to Control Multidrug-Resistant Avian Pathogenic Escherichia coli and Biofilms. Antibiotics, 13(11), 1083. https://doi.org/10.3390/antibiotics13111083

